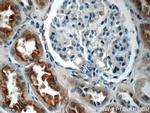
IQSEC2 Antibody in Immunohistochemistry (Paraffin) (IHC (P))

Search
Proteintech
IQSEC2 Polyclonal Antibody
{{$productOrderCtrl.translations['antibody.pdp.commerceCard.promotion.promotions']}}
{{$productOrderCtrl.translations['antibody.pdp.commerceCard.promotion.viewpromo']}}
{{$productOrderCtrl.translations['antibody.pdp.commerceCard.promotion.promocode']}}: {{promo.promoCode}} {{promo.promoTitle}} {{promo.promoDescription}}. {{$productOrderCtrl.translations['antibody.pdp.commerceCard.promotion.learnmore']}}
产品信息
25321-1-AP
种属反应
宿主/亚型
分类
类型
抗原
偶联物
形式
浓度
规格
纯化类型
保存液
内含物
保存条件
运输条件
产品详细信息
Immunogen sequence: FEEYEKAQN PAYFEGKPAS LDEGAMAGAR SHRLERGLPY GGSCGGGIDG GGSSVTTSGE FSNDITELED SFSKQVKSLA ESIDEALNCH PSGPMSEEPG SAQLEKRESK EQQEDSSATS FSDLPLYLDD TVPQQSPERL PSTEPPPQGR PEFWAPAPLP PVPPPVPSGT REDGSREEGT RRGPGCLECR DFRLRAAHL (189-386 aa encoded by BC156683)
靶标信息
This gene encodes a guanine nucleotide exchange factor for the ARF family of small GTP-binding proteins. The encoded protein is a component of the postsynaptic density at excitatory synapses, and may play a critical role in cytoskeletal and synaptic organization through the activation of selected ARF substrates including ARF1 and ARF6. Mutations in this gene have been implicated in nonsyndromic X-linked mental retardation. Alternatively spliced transcript variants encoding multiple isoforms have been observed for this gene.
仅用于科研。不用于诊断过程。未经明确授权不得转售。
篇参考文献 (0)
生物信息学
蛋白别名: BRAG1b; IQsec2; BRAG1c; IQSec2; brefeldin A resistant Arf-guanine nucleotide exchange factor 1; brefeldin A resistant Arf-guanine nucleotide exchange factor 1b; brefeldin A resistant Arf-guanine nucleotide exchange factor 1c; IQ motif and Sec7 domain 2; IQ motif and SEC7 domain-containing protein 2; IQsec2; unnamed protein product
基因别名: BRAG1; IQ-ArfGEF; IQSEC2; KIAA0522; MRX1; MRX18; MRX78; XLID1
UniProt ID: (Human) Q5JU85
Entrez Gene ID: (Human) 23096